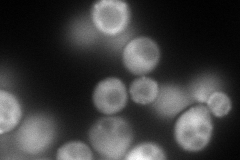
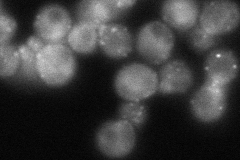

View description
Actin-associated protein, interacts with Rvs161p to regulate actin cytoskeleton, endocytosis, and viability following starvation or osmotic stress; homolog of mammalian amphiphysin
Localization:
Intensity:
Fold change:
Significance:
-
C’ GFP library in SD

below threshold16.57 -
N' NOP1pr-GFP in SD
cytosol,punctate222.982 -
N' TEF2pr-mCherry in SD

cytosol,punctate217.881 -
N' NATIVEpr-GFP in SD
punctate,bud neck75.3526 -
N' TEF2pr-VC and Cyto-VN in SD

cytosol55.2858 -
C’ GFP library in SD+DTT

cytosol19.231.16No -
C’ GFP library in SD+H2O2

cytosol17.021.02No -
C’ GFP library in Starvation Media

cytosol16.160.97No -
C’ GFP library on the background of Pup2-DaMP

below threshold -
C’ GFP library on the background of CCT mutant

below threshold16.97241.02387No
